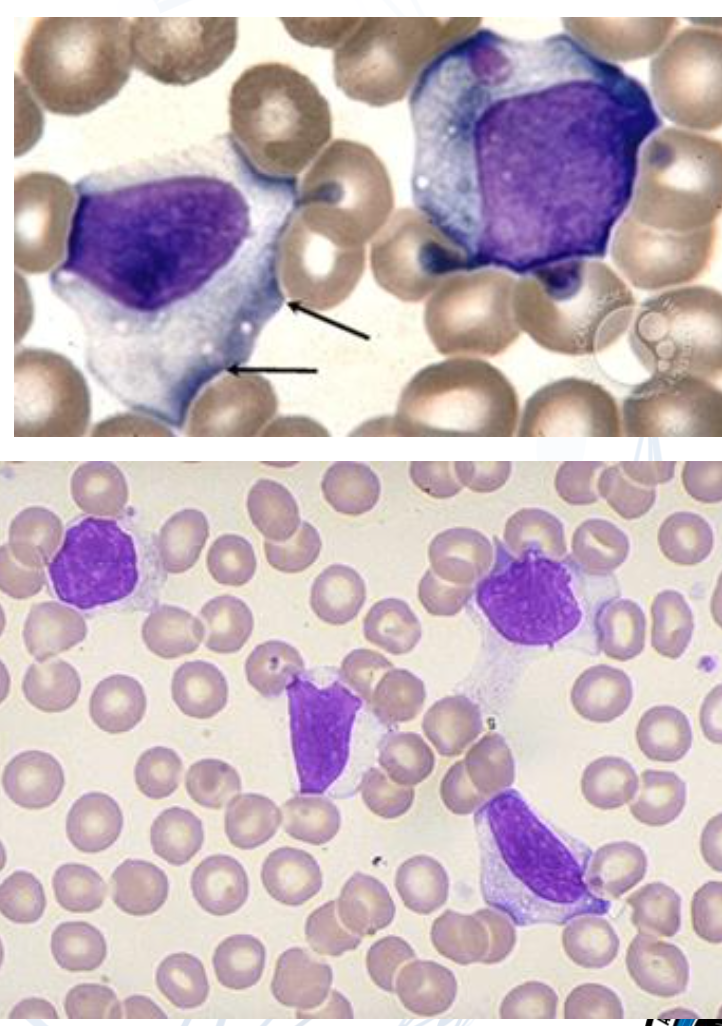
term image
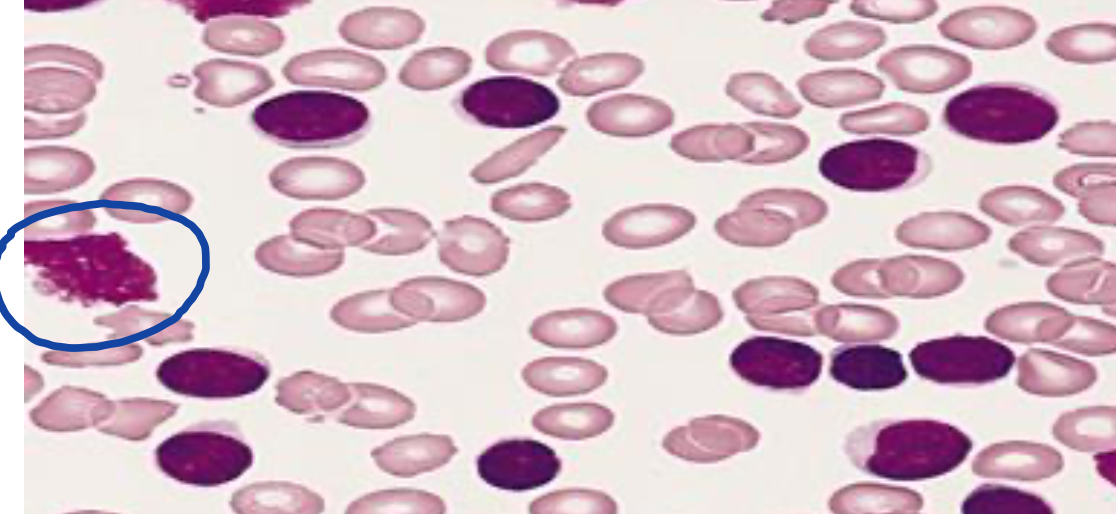
term image

1/16
Looks like no tags are added yet.
Name | Mastery | Learn | Test | Matching | Spaced | Call with Kai |
|---|
No analytics yet
Send a link to your students to track their progress
Mention causes of decreased production of neutropenia.
– Bone marrow diseases
– Malignancies that affect the bone marrow – Chemotherapy
Mention causes of basophilia.
Allergic or hypersensitivity reactions
Inflammatory disorders (collagen disorders)
Myeloproliferative disorders esp. CML
Basophilic leukemia
How to confirm infectious mononucleosis?
EBV serological tests
Infectious Mononucleosis.
What is the most common cancer in children?
ALL
Mention FAB classification for acute lymphocytic leukemia.

Which all affect males more than females?
ALL with T cell lineage
Mention important characteristics of promyelocytic leukemia.
Associated with disseminated intravascular coagulation (DIC)
Characteristic cells containing bundles of Auer rods randomly distributed within the cytoplasm are present in most cases.
• The sensitivity of APL cells to tretinoin (also called all-trans retinoic acid) or ATRA has led to the discovery that the RARA gene on 17q21.2 fuses with a nuclear regulatory factor gene on 15q24.1 (PML), giving rise to a PML- RARA fusion gene product

Promyelocytes in promyelocytic leukemia
Mature B-cell neoplasms are conditions where a clone of identical, mature B-lymphocytes proliferates, often indicated by …
Mature B-cell neoplasms are conditions where a clone of identical, mature B-lymphocytes proliferates, often indicated by kappa (K) or lambda (L) light chain restriction
Mention important lab mark in CLL.
presence of more than or equal to 5 × 109/L clonal B lymphocytes in the peripheral blood.
Smudge cell of CLL
Mention important CD markers in CLL.
The typical CLL cells co-express the T-cell antigen CD5 and the B-cell surface antigens CD19, CD20, and CD23.
negative for FMC7.
Mention an important method for differentiation of CLL from other lymphocytic disorders.
The differentiation between CLL and other lymphoma will depend on CLL scoring system of its immunophenotypic markers. The majority of CLL cases have a score of 4 or 5 whereas non-CLL cases score below 3.
Mention a characteristic lab finding in hairy cell leukemia.
Monocytopenia is characteristic.
Mention features of plasma cell dyscrasia.
(a clone of immunoglobulin-secreting)
The secreted monoclonal Immunoglobulin is called M protein, and its presence is called Monoclonal gammopathy.
Organ Damage; CRAB
Calcium High, Renal Affection, Anemia, Bone Damage
Mention diagnosis of plasma cell leukemia.
The diagnosis is based upon the percentage (≥ 20%)